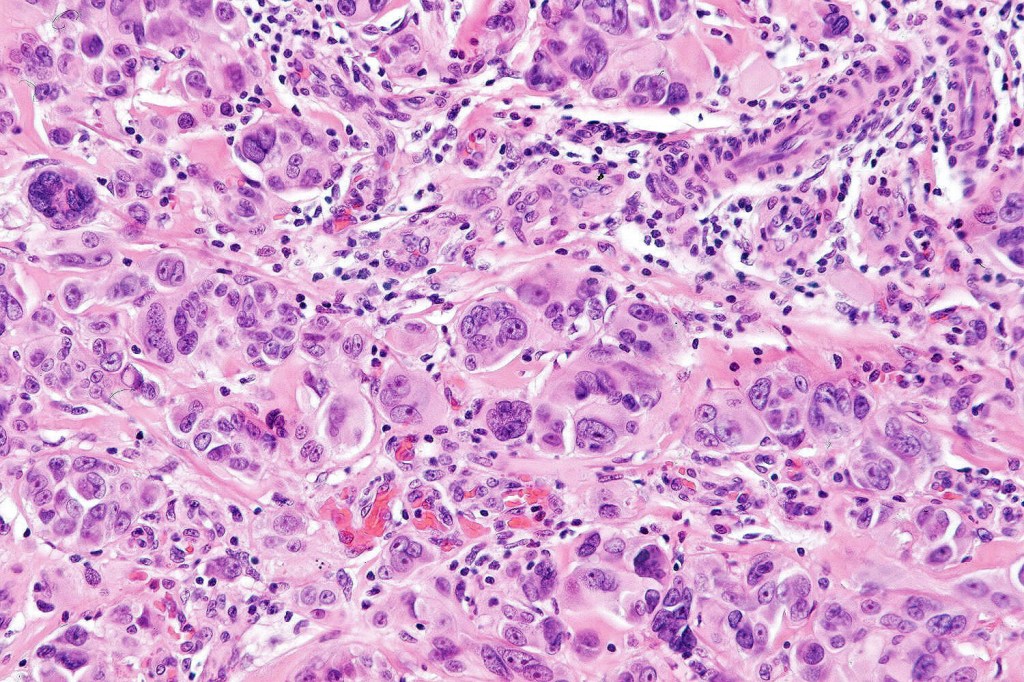
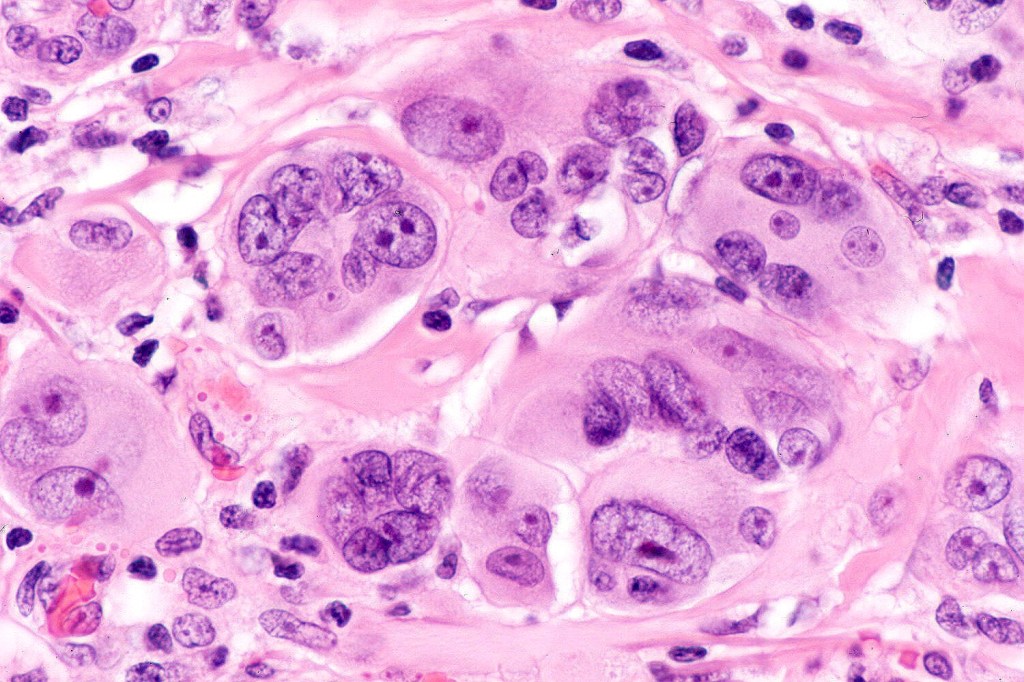
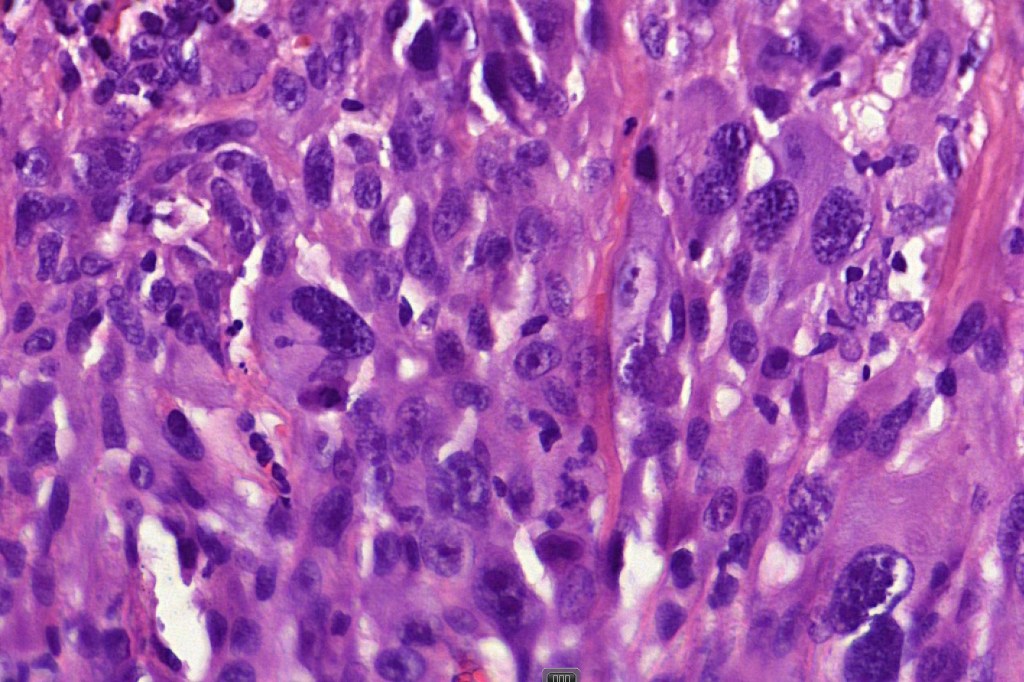
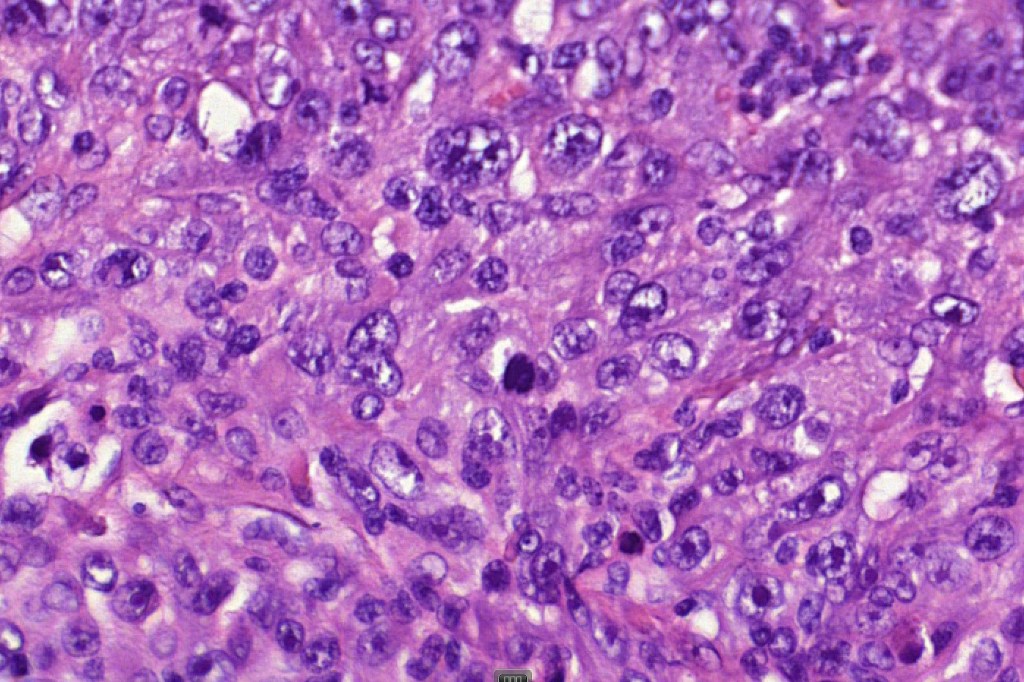
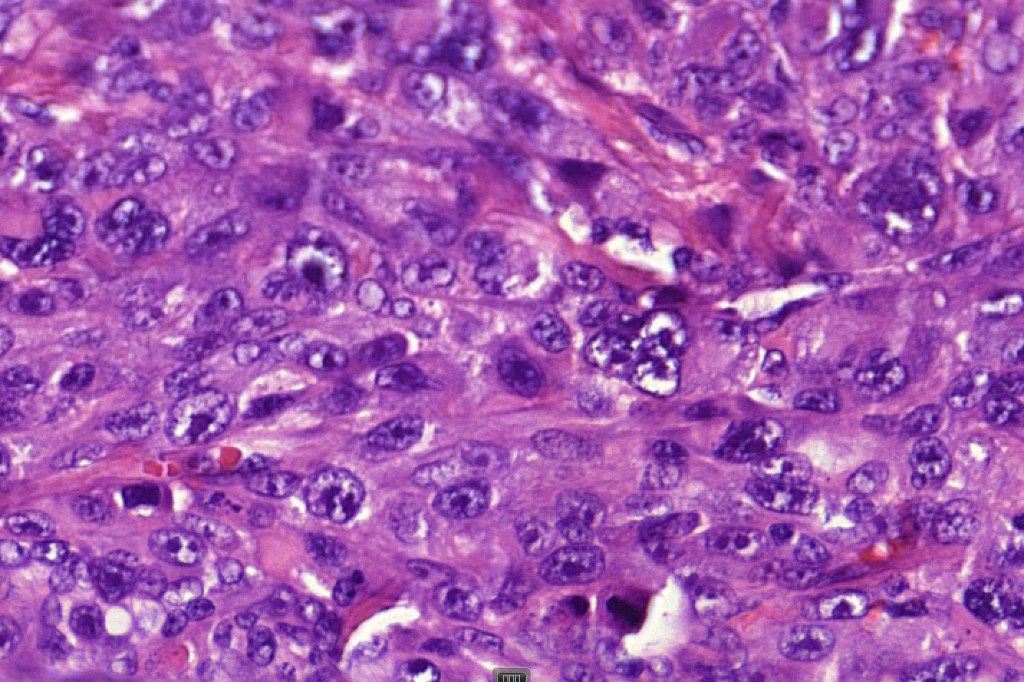
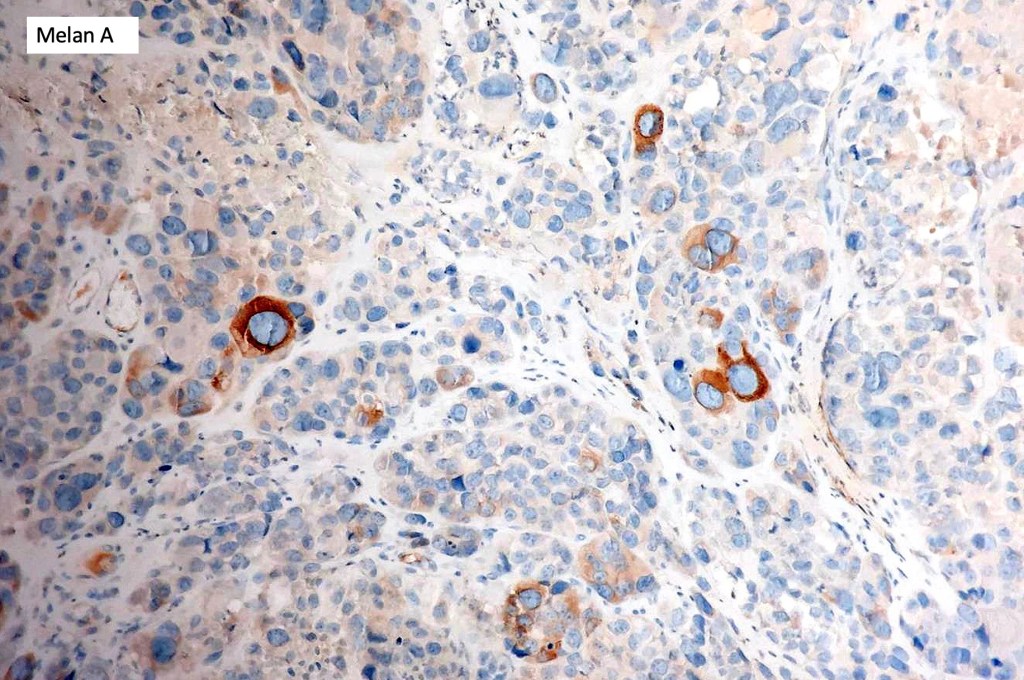

These are very rare variants of amelanotic or virtually amelanotic melanoma where a primary melanoma or a metastasis shows partial (DN) or complete loss (UN) of recognizable histological and immunohistochemical features. The histology may lead the pathologists to consider lymphoma, sarcoma, anaplastic carcinoma or a small cell tumor. Some examples of rhabdoid melanoma & melanoma with heterologous differentiation probably belong in this category. Ultimately, if there is no identifiable/recognizable primary tumor, diagnosis may only be comfortably made with next-generation sequencing. In the cases presented below, immunohistochemistry was of value in determining the melanoctic nature of the tumor (undifferentiated melanoma).

Leave a comment